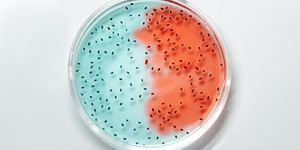

Matching a Specific Dissociation Enzyme to a Cell/Tissue?
With over 75 years of enzyme technology expertise, look no further than Worthington, the primary enzyme producer. Our extensive technical-resource library is the definitive source for primary cell isolation protocols and citations across a wide range of applications.
Figure 1: A scale showing the relative digestive power of the enzymes commonly used is shown above for reference. Refer to this scale when troubleshooting a dissociation and planning isolation strategy.
Now Available the Tissue Dissociation Guide In-print or On-line
Worthington’s Tissue Dissociation Guide describes standard lab procedures; offers a logical experimental approach for establishing an optimal cell isolation protocol; and lists many tissue-specific references to aid development of an effective method. Available online, this technical guide covers cell isolation theory, cell isolation techniques and optimization strategies with additional resources. For a print copy go to: https://www.worthington-biochem.com/support
In general, it is important to note, there is an area of optimized recovery balanced between yield and viability; working near the middle of this range will reduce variability in the results of the cell isolation procedure. Understanding this relationship and how it can vary with a particular cell type and application, can make the optimization process easier. For troubleshooting purposes various possible results, along with suggested corrective actions are listed below. Keep in mind that there are no clear lines between the quadrants but rather converging zones with variable areas of overlap.
Figure 2: For more information go to: https://www.worthington-biochem.com/tools-resources/tissue-dissociation-guide/optimization-techniques-general-guidelines
Worthington Offers Researchers More
Many years ago, we found that the most practical approach for the researcher is to pre-sample several different lots of collagenase at a time and select the best of the group for their specific use. As the world's leading manufacturer of collagenase, Worthington is able to offer the greatest number of different lots at any given time and recommend specific lots for most applications.
- Current Available Lots with Activity Profiles
- Interactive Collagenase Lot Selection Tool
- Online Collagenase Sample Request Form
For more information go to: https://www.worthington-biochem.com/support/collagenase-sampling-program
Use-Tested Cell Isolation Systems
For current citations on the Worthington Papain Dissociation System go to: https://www.worthington-biochem.com/products/papain-dissociation-system/manual
Worthington also currently offers Cell Isolation Systems which are kits containing enzymes and other required reagents for performing tissue dissociations without having to purchase individual packages of one or more enzymes and pretesting various lots of some enzymes. Some are designed for working with specific tissues, and one kit is a general-purpose protocol development system. In all cases, the enzymes which are included in the kits are standard Worthington products which can be purchased independently. Current kits include:
Cell Isolation Optimizing System (CIT)
Hepatocyte Isolation System (HIS)
Neonatal Cardiomyocyte Isolation System (NCIS)
Papain Dissociation System (PDS)
For an introduction to enzyme technology, access our YouTube video: